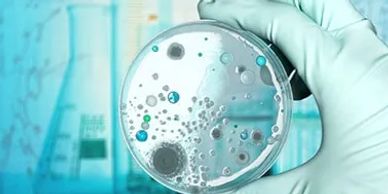

Cenric Pharmaceuticals is dedicated to combating infectious diseases through a robust portfolio of anti-infective therapies. We provide a wide range of antibiotics that address conditions such as urinary tract infections, post-surgical infections, viral colds, flu, bronchitis, etc.

Cenric Pharmaceuticals is dedicated to addressing the growing global burden of cardiovascular and diabetic conditions through its Cardio-Diabetic Therapeutic Area. We develop and offer a comprehensive range of medications that target the intersection of cardiovascular diseases and diabetes, which are often coexisting conditions

Cenric Pharmaceuticals is committed to advancing children's health by offering safe and effective medications tailored to the needs of pediatric patients. Our pediatric range includes formulations for

Cenric Pharmaceuticals is dedicated to supporting women’s health through a comprehensive range of gynaecological treatments. Our gynaecology therapeutic area focuses on addressing key health concerns at various stages of a woman’s life,providing solutions for:
Hormonal Imbalance, Menopause Management, Gynaecological Infections etc

In the field of Orthopedics, Cenric Pharmaceuticals develops medications that assist in the treatment of bone and joint disorders. Our products cater to:

Our gastroenterology portfolio addresses a wide spectrum of digestive health conditions, focusing on treatments for:
Cenric's solutions are aimed at improving digestive health and enhancing patient well-being.
We use cookies to analyze website traffic and optimize your website experience. By accepting our use of cookies, your data will be aggregated with all other user data.